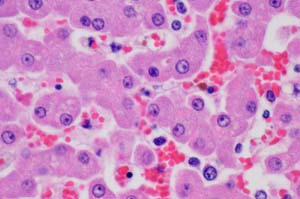
60x_20D_IMG_4308

|

|

|
| 40x_20D_IMG_4310.jpg | 40x_40D_IMG_0211.jpg | 40x_XTi_IMG_0226.jpg |

|

|

|
| 60x_20D_IMG_4308.jpg | 60x_40D_IMG_0212.jpg | 60x_XTi_IMG_0227.jpg |
| Photomicroscopy |

|

|

|
| 40x_20D_IMG_4310.jpg | 40x_40D_IMG_0211.jpg | 40x_XTi_IMG_0226.jpg |
|

|

|
| 60x_20D_IMG_4308.jpg | 60x_40D_IMG_0212.jpg | 60x_XTi_IMG_0227.jpg |